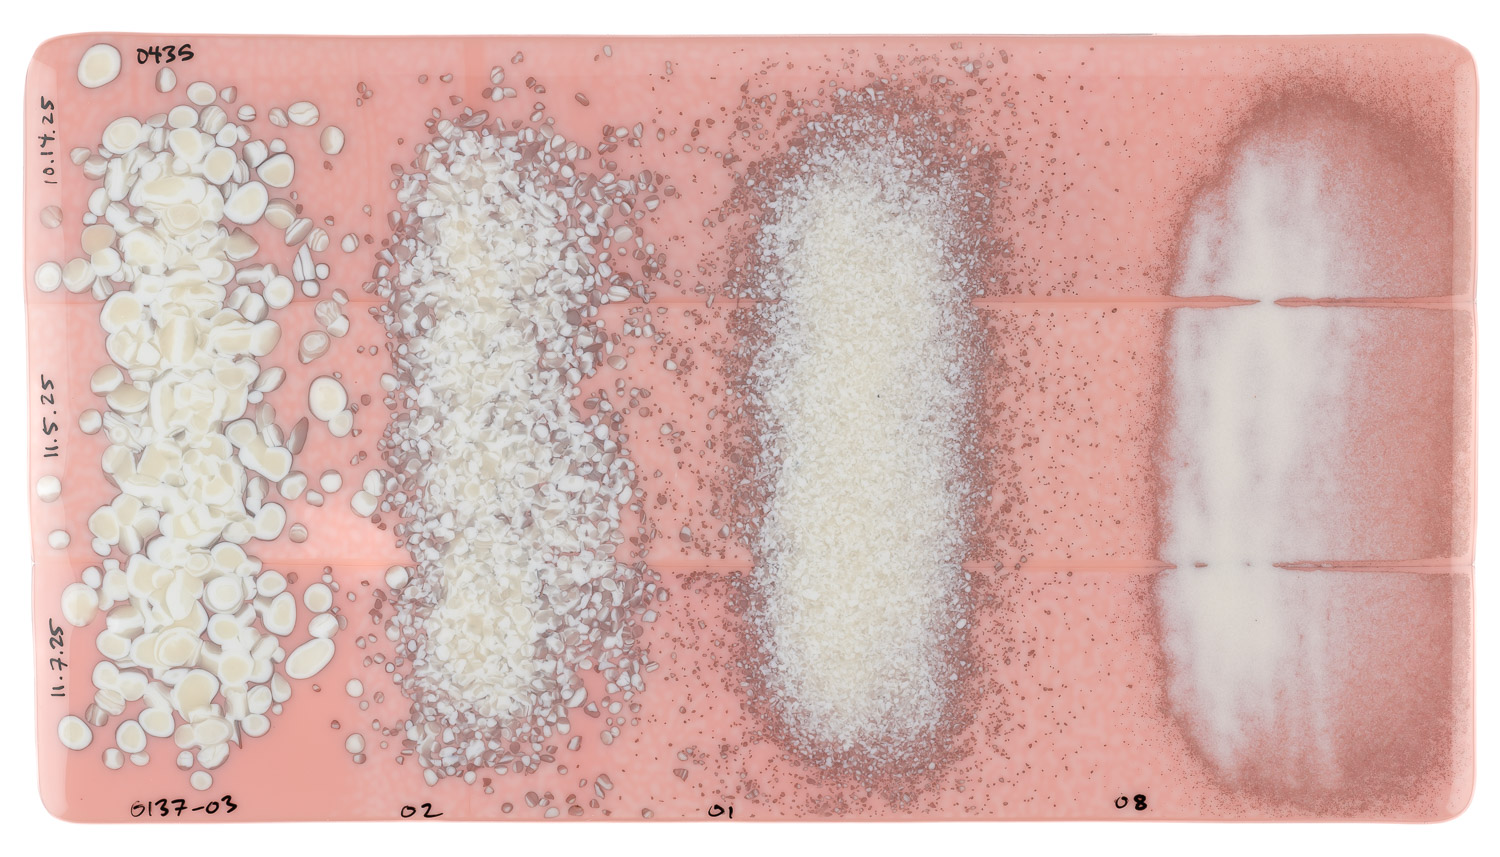

Overview

Striker
This style may not reveal (strike to) its target color until fired.
Reactive Potential
Contains: Lead (Pb)
May React With: Selenium (Se) / Sulfur (S)
Forms of Glass
Sheet Glass (-0030)
Detailed Information
About 000435 Sheet Glass
Cold Characteristics

Surface color variations common with color ranging from warm white to peach with variegated streaks. Underside of sheet can show patches of light and dark patterning from the forming process.
Working Notes

Matures to pastel peach upon firing, often with mottles and streaks remaining. Additionally, this style often fires with paler and darker hues and is not uniform in color. Underside of sheet can show patches of light and dark patterning from the forming process.
Interface reaction possible with sulfur glasses, particularly 000137 French Vanilla Opal.
Bullseye Compatible.
